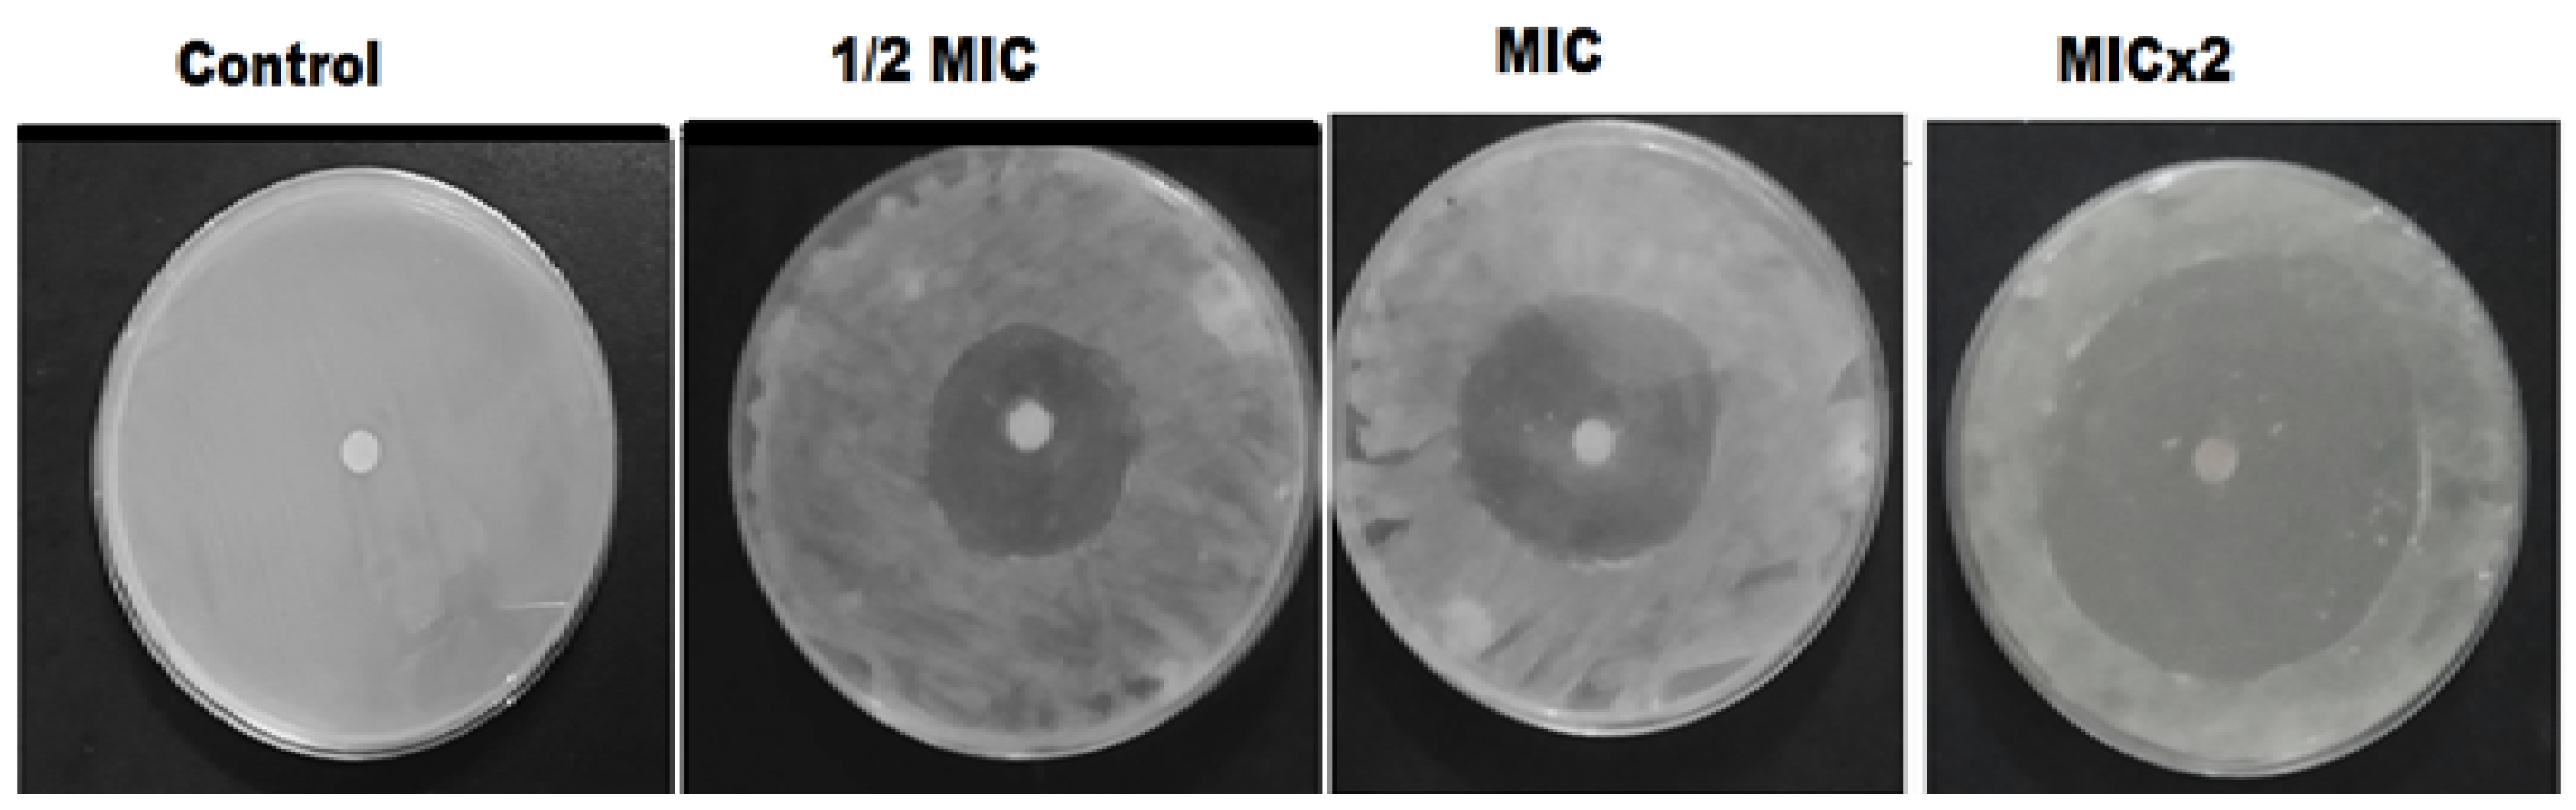
Pharmaceutics 14 01719 g006 550

RETRACTED: Moringa concanensis-Mediated Synthesis and Characterizations of Ciprofloxacin Encapsulated into Ag/TiO2/Fe2O3/CS Nanocomposite: A Therapeutic Solution against Multidrug Resistant E. coli Strains of Livestock Infectious Diseases
Abstract
1. Introduction
2. Materials and Methods
2.1. Chemicals and Reagents
2.2. Apparatus
2.3. Isolation and Identification of MDR E. coli Strains
2.4. Antibiotic Sensitivity Testing (AST)
2.5. Plant Extract and Synthesis of the Nanoformulation (NDDS)
- Step 1: Green synthesis of TiO2, Fe2O3, and Ag NPs
- Step 2: Formation of Ag/TiO2/Fe2O3 ternary metallic nanocomposite
- Step 3: Synthesis of Ag/TiO2/Fe2O3/CS heteronanocomposite
- Step 4: Fabrication of CIP-Ag/TiO2/Fe2O3/CS nanoformulation
2.6. Characterization of Synthesized Nanomaterials
2.7. Drug Encapsulation Efficiency (EE) and Drug Loading (LC) in the NDDS
2.8. Determination of MIC for CIP-Ag/TiO2/Fe2O3/CS Nanoformulation
2.9. Ex-Vivo CIP Release Kinetics from the Prepared NDDS
2.10. Antimicrobial Activity of the Prepared NDDS
2.11. Effect of NDDS on the Bacterial Growth Kinetics
2.12. Live/Dead Assessment of NDDS-Treated MDR Pathogens
2.13. FESEM Analysis of NDDS-Treated MDR Pathogens
2.14. Ex-Vivo Biocompatibility of NDDS
2.15. In Vivo NDDS-Mediated Infection Control
2.15.1. Setup for the Experiment
2.15.2. Bacteriologic Analysis (CFU)
2.16. Histopathological and Biochemical Profile in Rabbits
2.17. Ethics Approval
2.18. Statistics
3. Results
3.1. Synthesis of Metallic NPs from Aqueous Leaf Extract of Moringa Concanensis
3.2. Morphological Aspects and Elemental Composition of the NDDS
3.3. XRD Analysis
3.4. FTIR Analysis
3.5. ZP Analysis
3.6. EE and LC of CIP in Ag/TiO2/Fe2O3/CS Heteronanocomposite
3.7. In Vitro Antimicrobial Activity of NDDS
3.8. Growth Kinetics of MDR Strains-Causing Mastitis Treated by NDDS
3.9. Flow Cytometry of MDR E. coli-Induced Mastitis Treated with NDDS
3.10. Morphological Changes of MDR E. coli-Induced Mastitis Treated with NDDS
3.11. Cytotoxicity Mediated by NDDS
3.12. In Vivo Antimicrobial Activity of NDDS
3.13. In Vivo Biocompatibility of NDDS
3.14. In Vivo CIP Release Kinetics from NDDS
3.15. Proposed Mechanism of Action of NDDS against MDR E. coli
4. Conclusions
Author Contributions
Funding
Institutional Review Board Statement
Informed Consent Statement
Data Availability Statement
Conflicts of Interest
Abbreviations
| Ag | Silver |
| AgNO3 | Silver nitrate |
| AMR | Antimicrobial resistance |
| AST | Antibiotic sensitivity testing |
| BMGE | Bovine mammary gland epithelial cells |
| dH20 | Distilled water |
| DMEM | Dulbecco’s modified Eagle medium |
| CFU | Colony-forming unit |
| CIP | Ciprofloxacin (fluoroquinolone antibiotic) |
| CMT | California mastitis Test |
| CS | Chitosan |
| CXB | Celecoxib (COX-2 inhibitor) |
| DDM | Disk diffusion method |
| DMEM | Dulbecco’s modified Eagle medium |
| DMSO | Dimethylsulfoxide |
| E. coli | Escherichia coli |
| EDTA | Ethylenediaminetetraacetic acid |
| EDX/A | Energy dispersive X-ray/analyzer; also called EDS = EDX spectroscopy |
| FACS | Fluorescence-activated cell sorting |
| FTIR | Fourier-transform infrared spectroscopy |
| GA | Glutaraldehyde |
| Fe2O3 | Iron oxide |
| i.p. | Intraperitoneal |
| MHA | Mueller–Hinton agar |
| MHB | Mueller–Hinton broth |
| MIC | Minimum inhibitory concentration |
| MTT | 3-(4, 5-dimethylthiazol-2-yl)-2, 5-diphenyl tetrazolium bromide |
| NA | Nutrient agar |
| NB | Nutrient broth |
| NC | Negative control |
| NDDS | Nanoparticulate drug delivery system |
| NPs | Nanoparticles |
| OD | Optical density |
| PBP | Penicillin-binding protein |
| PC | Positive control |
| PI | Propidium iodide |
| ROS | Reactive oxygen species |
| RT | Room temperature |
| SEM | Scanning electron microscopy |
| SD | Standard deviation |
| TiO2 | Titanium dioxide |
| TTP | Titanium tetra isoproxide |
| TPP | Tripolyphosphate |
| Vs | Versus |
| XRD | X-ray diffractometer |
| ZI | Zone of inhibition |
| ZP | Zeta potential |
References
- Zafar, N.; Uzair, B.; Niazi, M.B.K.; Menaa, F.; Samin, G.; Khan, B.A.; Iqbal, H.; Menaa, B. Green synthesis of ciprofloxacin-loaded cerium oxide/chitosan nanocarrier and its activity against MRSA-induced mastitis. J. Pharm. Sci. 2021, 110, 3471–3483. [Google Scholar] [CrossRef]
- Zafar, N.; Uzair, B.; Niazi, M.B.K.; Samin, G.; Bano, A.; Jamil, N.; Sajjad, S.; Menaa, F. Synthesis and characterization of potent and safe ciprofloxacin-loaded Ag/TiO2/CS nanohybrid against mastitis causing E. coli. Crystals 2021, 11, 319. [Google Scholar] [CrossRef]
- Ashraf, A.; Imran, M. Causes, types, etiological agents, prevalence, diagnosis, treatment, prevention, effects on human health and future aspects of bovine mastitis. Anim. Health Res. Rev. 2020, 21, 36–49. [Google Scholar] [CrossRef] [PubMed]
- Bankier, C.; Cheong, Y.-K.; Mahalingam, S.; Edirisinghe, M.; Ren, G.; Cloutman-Green, E.; Ciric, L. A comparison of methods to assess the antimicrobial activity of nanoparticle combinations on bacterial cells. PLoS ONE 2018, 13, e0192093. [Google Scholar] [CrossRef] [PubMed]
- Lu, H.D.; Yang, S.S.; Wilson, B.K.; McManus, S.A.; Chen, C.V.-H.; Prud’homme, R.K. Nanoparticle targeting of Gram-positive and Gram-negative bacteria for magnetic-based separations of bacterial pathogens. Appl. Nanosci. 2017, 7, 83–93. [Google Scholar] [CrossRef]
- Iqbal, H.; Razzaq, A.; Uzair, B.; Ain, N.U.; Sajjad, S.; Althobaiti, N.A.; Albalawi, A.E.; Menaa, B.; Haroon, M.; Khan, M.; et al. Breast Cancer Inhibition by Biosynthesized Titanium Dioxide Nanoparticles Is Comparable to Free Doxorubicin but Appeared Safer in BALB/c Mice. Materials 2021, 14, 3155. [Google Scholar] [CrossRef] [PubMed]
- Mohamed, J.M.M.; Alqahtani, A.; Kumar, T.V.A.; Al Fatease, A.; Alqahtani, T.; Krishnaraju, V.; Ahmad, F.; Menaa, F.; Alamri, A.; Muthumani, R.; et al. Superfast Synthesis of Stabilized Silver Nanoparticles Using Aqueous Allium sativum (Garlic) Extract and Isoniazid Hydrazide Conjugates: Molecular Docking and In-Vitro Characterizations. Molecules 2021, 27, 110. [Google Scholar] [CrossRef] [PubMed]
- Singh, J.; Dutta, T.; Kim, K.-H.; Rawat, M.; Samddar, P.; Kumar, P. ‘Green’synthesis of metals and their oxide nanoparticles: Applications for environmental remediation. J. Nanobiotechnol. 2018, 16, 84. [Google Scholar] [CrossRef]
- Ul Haq, M.N.; Shah, G.M.; Menaa, F.; Khan, R.A.; Althobaiti, N.A.; Albalawi, A.E.; Alkreathy, H.M. Green Silver Nanoparticles Synthesized from Taverniera couneifolia Elicits Effective Anti-Diabetic Effect in Alloxan-Induced Diabetic Wistar Rats. Nanomaterials 2022, 12, 1035. [Google Scholar] [CrossRef]
- Uzair, B.; Liaqat, A.; Iqbal, H.; Menaa, B.; Razzaq, A.; Thiripuranathar, G.; Rana, N.F.; Menaa, F. Green and Cost-Effective Synthesis of Metallic Nanoparticles by Algae: Safe Methods for Translational Medicine. Bioengineering 2020, 7, 129. [Google Scholar] [CrossRef]
- Padla, E.P.; Solis, L.T.; Levida, R.M.; Shen, C.-C.; Ragasa, C.Y. Antimicrobial isothiocyanates from the seeds of Moringa oleifera Lam. Z. Naturforsch. C 2012, 67, 557–564. [Google Scholar] [CrossRef]
- Waterman, C.; Rojas-Silva, P.; Tumer, T.B.; Kuhn, P.; Richard, A.J.; Wicks, S.; Stephens, J.M.; Wang, Z.; Mynatt, R.; Cefalu, W. Isothiocyanate-rich Moringa oleifera extract reduces weight gain, insulin resistance, and hepatic gluconeogenesis in mice. Mol. Nutr. Food Res. 2015, 59, 1013–1024. [Google Scholar] [CrossRef]
- Abd Rani, N.Z.; Husain, K.; Kumolosasi, E. Moringa Genus: A Review of Phytochemistry and Pharmacology. Front. Pharmacol. 2018, 9, 108. [Google Scholar] [CrossRef]
- Anderson, V.E.; Gootz, T.D.; Osheroff, N. Topoisomerase IV catalysis and the mechanism of quinolone action. J. Biol. Chem. 1998, 273, 17879–17885. [Google Scholar] [CrossRef]
- Van der Putten, B.C.L.; Remondini, D.; Pasquini, G.; Janes, V.A.; Matamoros, S.; Schultsz, C. Quantifying the contribution of four resistance mechanisms to ciprofloxacin MIC in Escherichia coli: A systematic review. J. Antimicrob. Chemother. 2018, 74, 298–310. [Google Scholar] [CrossRef]
- Kalaivani, R.; Maruthupandy, M.; Muneeswaran, T.; Beevi, A.H.; Anand, M.; Ramakritinan, C.; Kumaraguru, A. Synthesis of chitosan mediated silver nanoparticles (Ag NPs) for potential antimicrobial applications. Front. Lab. Med. 2018, 2, 30–35. [Google Scholar] [CrossRef]
- Ali, A.H.; Alheety, M.A.; Hasen Alubaidy, M.; Dohare, S. Nano drug (AgNPs capped with hydroxychloroquine): Synthesis, characterization, anti-COVID-19 and healing the wound infected with S. aureus. Mater. Chem. Phys. 2022, 287, 126249. [Google Scholar] [CrossRef]
- Zhao, Z.Y.; Li, P.J.; Xie, R.S.; Cao, X.Y.; Su, D.L.; Shan, Y. Biosynthesis of silver nanoparticle composites based on hesperidin and pectin and their synergistic antibacterial mechanism. Int. J. Biol. Macromol. 2022, 214, 220–229. [Google Scholar] [CrossRef]
- Zafar, N.; Uzair, B.; Niazi, M.B.K.; Sajjad, S.; Samin, G.; Arshed, M.J.; Rafiq, S. Fabrication & characterization of chitosan coated biologically synthesized TiO2 nanoparticles against PDR E. coli of veterinary origin. Adv. Polym. Technol. 2020, 2020, 8456024. [Google Scholar]
- Li, S.; Cai, J.; Wu, X.; Zheng, F. Sandwich-like TiO2@ ZnO-based noble metal (Ag, Au, Pt, or Pd) for better photo-oxidation performance: Synergistic effect between noble metal and metal oxide phases. Appl. Surf. Sci. 2018, 443, 603–612. [Google Scholar] [CrossRef]
- Zielińska-Jurek, A.; Wei, Z.; Wysocka, I.; Szweda, P.; Kowalska, E. The effect of nanoparticles size on photocatalytic and antimicrobial properties of Ag-Pt/TiO2 photocatalysts. Appl. Surf. Sci. 2015, 353, 317–325. [Google Scholar] [CrossRef]
- Saranya, A.; Thamer, A.; Ramar, K.; Priyadharsan, A.; Raj, V.; Murugan, K.; Murad, A.; Maheshwaran, P. Facile one pot microwave-assisted green synthesis of Fe2O3/Ag nanocomposites by phytoreduction: Potential application as sunlight-driven photocatalyst, antibacterial and anticancer agent. J. Photochem. Photobiol. B Biol. 2020, 207, 111885. [Google Scholar]
- Mohamed, H.H.; Alomair, N.A.; Akhtar, S.; Youssef, T.E. Eco-friendly synthesized α-Fe2O3/TiO2 heterojunction with enhanced visible light photocatalytic activity. J. Photochem. Photobiol. A Chem. 2019, 382, 111951. [Google Scholar] [CrossRef]
- Razani, A.; Abdullah, A.H.; Fitrianto, A.; Yusof, N.A.; Gaya, U.I. Sol-gel synthesis of Fe2O3-doped TiO2 photocatalyst for optimized photocatalytic degradation of 2, 4-dichlorophenoxyacetic acid. Orient. J. Chem. 2017, 33, 1959. [Google Scholar] [CrossRef]
- Fahlepy, M.R.; Wahyuni, Y.; Andhika, M.; Vistarani, A.T. Subaer Synthesis and Characterization of Nanopraticle Hematite (α-Fe2O3) Minerals from Natural Iron Sand Using Co-Precipitation Method and its Potential Applications as Extrinsic Semiconductor Materials Type-N. Mater. Sci. Forum 2019, 967, 259–266. [Google Scholar] [CrossRef]
- Thukkaram, M.; Sitaram, S.; Subbiahdoss, G. Antibacterial efficacy of iron-oxide nanoparticles against biofilms on different biomaterial surfaces. Int. J. Biomater. 2014, 2014, 716080. [Google Scholar] [CrossRef] [PubMed]
- Vega-Jiménez, A.L.; Vázquez-Olmos, A.R.; Acosta-Gío, E.; Álvarez-Pérez, M.A. In vitro antimicrobial activity evaluation of metal oxide nanoparticles. In Nanoemulsions: Properties, Fabrications and Applications; IntechOpen: London, UK, 2019; pp. 1–18. [Google Scholar]
- Iqbal, H.; Khan, B.A.; Khan, Z.U.; Razzaq, A.; Khan, N.U.; Menaa, B.; Menaa, F. Fabrication, physical characterizations and in vitro antibacterial activity of cefadroxil-loaded chitosan/poly(vinyl alcohol) nanofibers against Staphylococcus aureus clinical isolates. Int. J. Biol. Macromol. 2020, 144, 921–931. [Google Scholar] [CrossRef] [PubMed]
- Khan, M.K.; Khan, B.A.; Uzair, B.; Niaz, S.I.; Khan, H.; Hosny, K.M.; Menaa, F. Development of Chitosan-Based Nanoemulsion Gel Containing Microbial Secondary Metabolite with Effective Antifungal Activity: In Vitro and In Vivo Characterizations. Int. J. Nanomed. 2021, 16, 8203–8219. [Google Scholar] [CrossRef]
- Zhao, S. Chitosan-Coated Cerium Oxide Nanoparticles and Sparfloxacin Encapsulated Polymersomes as a New Drug System with Antimicrobial Properties. Master’s Thesis, Northeastern University Boston, Boston, MA, USA, 2018. [Google Scholar]
- Raza, Z.A.; Khalil, S.; Ayub, A.; Banat, I.M. Recent developments in chitosan encapsulation of various active ingredients for multifunctional applications. Carbohydr. Res. 2020, 492, 108004. [Google Scholar] [CrossRef]
- Holt, J.G.; Krieg, N.; Sneath, P.H.; Staley, J.; Williams, S. Bergey’s Manual of Determinative Bacteriology, 9th ed.; William & Wilkins: Baltimore, MD, USA, 1994. [Google Scholar]
- Unnerstad, H.E.; Lindberg, A.; Waller, K.P.; Ekman, T.; Artursson, K.; Nilsson-Öst, M.; Bengtsson, B. Microbial aetiology of acute clinical mastitis and agent-specific risk factors. Vet. Microbiol. 2009, 137, 90–97. [Google Scholar] [CrossRef]
- Ahmed, S.; Ahmad, M.; Swami, B.L.; Ikram, S. A review on plants extract mediated synthesis of silver nanoparticles for antimicrobial applications: A green expertise. J. Adv. Res. 2016, 7, 17–28. [Google Scholar] [CrossRef]
- Shameli, K.; Ahmad, M.B.; Yunus, W.Z.W.; Ibrahim, N.A.; Darroudi, M. Synthesis and characterization of silver/talc nanocomposites using the wet chemical reduction method. Int. J. Nanomed. 2010, 5, 743–751. [Google Scholar] [CrossRef]
- Jamil, B.; Habib, H.; Abbasi, S.A.; Ihsan, A.; Nasir, H.; Imran, M. Development of cefotaxime impregnated chitosan as nano-antibiotics: De novo strategy to combat biofilm forming multi-drug resistant pathogens. Front. Microbiol. 2016, 7, 330. [Google Scholar] [CrossRef]
- Yang, X.H.; Fu, H.T.; Wang, X.C.; Yang, J.L.; Jiang, X.C.; Yu, A.B. Synthesis of silver-titanium dioxide nanocomposites for antimicrobial applications. J. Nanopart. Res. 2014, 16, 2526. [Google Scholar] [CrossRef]
- Abreu, F.O.; Oliveira, E.F.; Paula, H.C.; de Paula, R.C. Chitosan/cashew gum nanogels for essential oil encapsulation. Carbohydr. Polym. 2012, 89, 1277–1282. [Google Scholar] [CrossRef]
- Luber, P.; Bartelt, E.; Genschow, E.; Wagner, J.; Hahn, H. Comparison of broth microdilution, E test, and agar dilution methods for antibiotic susceptibility testing of Campylobacter jejuni and Campylobacter coli. J. Clin. Microbiol. 2003, 41, 1062. [Google Scholar] [CrossRef]
- Birla, S.; Tiwari, V.; Gade, A.; Ingle, A.; Yadav, A.; Rai, M. Fabrication of silver nanoparticles by Phoma glomerata and its combined effect against Escherichia coli, Pseudomonas aeruginosa and Staphylococcus aureus. Lett. Appl. Microbiol. 2009, 48, 173–179. [Google Scholar] [CrossRef]
- O’Brien-Simpson, N.M.; Pantarat, N.; Attard, T.J.; Walsh, K.A.; Reynolds, E.C. A rapid and quantitative flow cytometry method for the analysis of membrane disruptive antimicrobial activity. PLoS ONE 2016, 11, e0151694. [Google Scholar] [CrossRef]
- Huang, X.; Bao, X.; Liu, Y.; Wang, Z.; Hu, Q. Catechol-functional chitosan/silver nanoparticle composite as a highly effective antibacterial agent with species-specific mechanisms. Sci. Rep. 2017, 7, 1860. [Google Scholar] [CrossRef]
- Mohammadi, F.; Golafshan, N.; Kharaziha, M.; Ashrafi, A. Chitosan-heparin nanoparticle coating on anodized NiTi for improvement of blood compatibility and biocompatibility. Int. J. Biol. Macromol. 2019, 127, 159–168. [Google Scholar] [CrossRef]
- Caputo, F.; Mameli, M.; Sienkiewicz, A.; Licoccia, S.; Stellacci, F.; Ghibelli, L.; Traversa, E. A novel synthetic approach of cerium oxide nanoparticles with improved biomedical activity. Sci. Rep. 2017, 7, 4636. [Google Scholar] [CrossRef]
- Mapara, M.; Thomas, B.S.; Bhat, K. Rabbit as an animal model for experimental research. Dent. Res. J. 2012, 9, 111. [Google Scholar]
- Zierdt, C.H.; Peterson, D.L.; Swan, J.C.; MacLowry, J.D. Lysis-filtration blood culture versus conventional blood culture in a bacteremic rabbit model. J. Clin. Microbiol. 1982, 15, 74–77. [Google Scholar] [CrossRef]
- Bancroft, J.D.; Gamble, M. Theory and Practice of Histological Techniques; Elsevier Health Sciences: Amsterdam, The Netherlands, 2008. [Google Scholar]
- Fodouop, S.P.C.; Tala, S.D.; Keilah, L.P.; Kodjio, N.; Yemele, M.D.; Nwabo, A.H.K.; Nji-Kah, B.; Tchoumboue, J.; Gatsing, D. Effects of Vitellaria paradoxa (CF Gaertn.) aqueous leaf extract administration on Salmonella typhimurium-infected rats. BMC Complement. Altern. Med. 2017, 17, 160. [Google Scholar] [CrossRef]
- Reitman, S.; Frankel, S. A Colorimetric Method for the Determination of Serum Glutamic Oxalacetic and Glutamic Pyruvic Transaminases. Am. J. Clin. Pathol. 1957, 28, 56–63. [Google Scholar] [CrossRef]
- Murray, R. Creatinine. In Clinical Chemistry: Theory, Analysis, and Correlation; CV Mosby Company: St. Louis, MO, USA, 1984. [Google Scholar]
- Ghassan, A.A.; Mijan, N.-A.; Taufiq-Yap, Y.H. Nanomaterials: An Overview of Nanorods Synthesis and Optimization. Nanorods Nanocompos. 2019, 11, 8–33. [Google Scholar] [CrossRef]
- Mustapha, T.; Misni, N.; Ithnin, N.R.; Daskum, A.M.; Unyah, N.Z. A Review on Plants and Microorganisms Mediated Synthesis of Silver Nanoparticles, Role of Plants Metabolites and Applications. Int. J. Environ. Res. Public Health 2022, 19, 674. [Google Scholar] [CrossRef]
- Adibelli, M.; Ozcelik, E.; Batibay, G.S.; Arasoglu, T.O.; Arsu, N. A facile and versatile route for preparation AgNp nanocomposite thin films via thiol-acrylate photopolymerization: Determination of antibacterial activity. Prog. Org. Coat. 2020, 143, 105620. [Google Scholar] [CrossRef]
- Yu, Z.; Moussa, H.; Liu, M.; Schneider, R.; Moliere, M.; Liao, H. Heterostructured metal oxides-ZnO nanorods films prepared by SPPS route for photodegradation applications. Surf. Coat. Technol. 2019, 375, 670–680. [Google Scholar] [CrossRef]
- Georgekutty, R.; Seery, M.K.; Pillai, S.C. A highly efficient Ag-ZnO photocatalyst: Synthesis, properties, and mechanism. J. Phys. Chem. C 2008, 112, 13563–13570. [Google Scholar] [CrossRef]
- Lei, B.-X.; Luo, Q.-P.; Yu, X.-Y.; Wu, W.-Q.; Su, C.-Y.; Kuang, D.-B. Hierarchical TiO2 flowers built from TiO2 nanotubes for efficient Pt-free based flexible dye-sensitized solar cells. Phys. Chem. Chem. Phys. 2012, 14, 13175–13179. [Google Scholar] [CrossRef]
- Li, J.; Xie, B.; Xia, K.; Li, Y.; Han, J.; Zhao, C. Enhanced antibacterial activity of silver doped titanium dioxide-chitosan composites under visible light. Materials 2018, 11, 1403. [Google Scholar] [CrossRef]
- Bokare, A.; Sanap, A.; Pai, M.; Sabharwal, S.; Athawale, A.A. Antibacterial activities of Nd doped and Ag coated TiO2 nanoparticles under solar light irradiation. Colloids Surf. B Biointerfaces 2013, 102, 273–280. [Google Scholar] [CrossRef]
- Hanna, D.H.; Saad, G.R. Encapsulation of ciprofloxacin within modified xanthan gum-chitosan based hydrogel for drug delivery. Bioorg. Chem. 2019, 84, 115–124. [Google Scholar] [CrossRef]
- Lynch, K.L. CLSI C62-A: A new standard for clinical mass spectrometry. Clin. Chem. 2016, 62, 24–29. [Google Scholar] [CrossRef]
- Burello, E.; Worth, A.P. A theoretical framework for predicting the oxidative stress potential of oxide nanoparticles. Nanotoxicology 2010, 5, 228–235. [Google Scholar] [CrossRef]
- Xia, T.; Kovochich, M.; Liong, M.; Mädler, L.; Gilbert, B.; Shi, H.; Yeh, J.I.; Zink, J.I.; Nel, A.E. Comparison of the mechanism of toxicity of zinc oxide and cerium oxide nanoparticles based on dissolution and oxidative stress properties. ACS Nano 2008, 2, 2121–2134. [Google Scholar] [CrossRef]
- Hussain, S.; Al-Nsour, F.; Rice, A.B.; Marshburn, J.; Yingling, B.; Ji, Z.; Zink, J.I.; Walker, N.J.; Garantziotis, S. Cerium dioxide nanoparticles induce apoptosis and autophagy in human peripheral blood monocytes. ACS Nano 2012, 6, 5820–5829. [Google Scholar] [CrossRef]
- Omolo, C.A.; Kalhapure, R.S.; Agrawal, N.; Jadhav, M.; Rambharose, S.; Mocktar, C.; Govender, T. A hybrid of mPEG-b-PCL and G1-PEA dendrimer for enhancing delivery of antibiotics. J. Control. Release 2018, 290, 112–128. [Google Scholar] [CrossRef]
- Saravanakumar, K.; Chelliah, R.; Shanmugam, S.; Varukattu, N.B.; Oh, D.-H.; Kathiresan, K.; Wang, M.-H. Green synthesis and characterization of biologically active nanosilver from seed extract of Gardenia jasminoides Ellis. J. Photochem. Photobiol. B Biol. 2018, 185, 126–135. [Google Scholar] [CrossRef]
- Wang, L.; He, H.; Yu, Y.; Sun, L.; Liu, S.; Zhang, C.; He, L. Morphology-dependent bactericidal activities of Ag/CeO2 catalysts against Escherichia coli. J. Inorg. Biochem. 2014, 135, 45–53. [Google Scholar] [CrossRef]
- De Campos, A.M.; Diebold, Y.; Carvalho, E.L.S.; Sánchez, A.; Alonso, M.J. Chitosan nanoparticles as new ocular drug delivery systems: In vitro stability, in vivo fate, and cellular toxicity. Pharm. Res. 2004, 21, 803–810. [Google Scholar] [CrossRef]
- El-Shafai, N.; El-Khouly, M.E.; El-Kemary, M.; Ramadan, M.; Eldesoukey, I.; Masoud, M. Graphene oxide decorated with zinc oxide nanoflower, silver and titanium dioxide nanoparticles: Fabrication, characterization, DNA interaction, and antibacterial activity. RSC Adv. 2019, 9, 3704–3714. [Google Scholar] [CrossRef]
- Arumugam, A.; Karthikeyan, C.; Hameed, A.S.H.; Gopinath, K.; Gowri, S.; Karthika, V. Synthesis of cerium oxide nanoparticles using Gloriosa superba L. leaf extract and their structural, optical and antibacterial properties. Mater. Sci. Eng. C 2015, 49, 408–415. [Google Scholar] [CrossRef]
- Prasad, R.; Rattan, G. Preparation methods and applications of CuO-CeO2 catalysts: A short review. Bull. Chem. React. Eng. Catal. 2010, 5, 7. [Google Scholar] [CrossRef]
- Todo, H. Transdermal Permeation of Drugs in Various Animal Species. Pharmaceutics 2017, 9, 33. [Google Scholar] [CrossRef]
- Costa, P.; Lobo, J.M.S. Modeling and comparison of dissolution profiles. Eur. J. Pharm. Sci. 2001, 13, 123–133. [Google Scholar] [CrossRef]
- Parikh, S.J.; Chorover, J. ATR-FTIR spectroscopy reveals bond formation during bacterial adhesion to iron oxide. Langmuir 2006, 22, 8492–8500. [Google Scholar] [CrossRef]
- Raghunath, A.; Perumal, E. Metal oxide nanoparticles as antimicrobial agents: A promise for the future. Int. J. Antimicrob. Agents 2017, 49, 137–152. [Google Scholar] [CrossRef]
- Ramalingam, B.; Parandhaman, T.; Das, S.K. Antibacterial effects of biosynthesized silver nanoparticles on surface ultrastructure and nanomechanical properties of gram-negative bacteria viz. Escherichia coli and Pseudomonas aeruginosa. ACS Appl. Mater. Interfaces 2016, 8, 4963–4976. [Google Scholar] [CrossRef]

| Antimicrobial Agents | Zone of Inhibitions (mm) |
|---|---|
| CIP-Ag/TiO2/Fe2O3/CS nanorods (NDDS) | 33 ± 1.40 |
| Ag/TiO2/Fe2O3/CS nanorods | 25 ± 2.11 |
| Ag/TiO2/Fe2O3 nanorods | 18 ± 1.84 |
| TiO2/Ag NPs | 12 ± 2.17 |
| TiO2 NPs | 4 ± 0.83 |
| Ag NPs | 9 ± 0.92 |
| Fe2O3 nanorods | 8 ± 1.60 |
| CS NPs | 3 ± 0.70 |
| CIP drug (PC) | - |
| DMSO (NC) | - |
Publisher’s Note: MDPI stays neutral with regard to jurisdictional claims in published maps and institutional affiliations. |
© 2022 by the authors. Licensee MDPI, Basel, Switzerland. This article is an open access article distributed under the terms and conditions of the Creative Commons Attribution (CC BY) license (https://creativecommons.org/licenses/by/4.0/).
Share and Cite
Zafar, N.; Uzair, B.; Menaa, F.; Khan, B.A.; Niazi, M.B.K.; Alaryani, F.S.; Majrashi, K.A.; Sajjad, S. RETRACTED: Moringa concanensis-Mediated Synthesis and Characterizations of Ciprofloxacin Encapsulated into Ag/TiO2/Fe2O3/CS Nanocomposite: A Therapeutic Solution against Multidrug Resistant E. coli Strains of Livestock Infectious Diseases. Pharmaceutics 2022, 14, 1719. https://doi.org/10.3390/pharmaceutics14081719
Zafar N, Uzair B, Menaa F, Khan BA, Niazi MBK, Alaryani FS, Majrashi KA, Sajjad S. RETRACTED: Moringa concanensis-Mediated Synthesis and Characterizations of Ciprofloxacin Encapsulated into Ag/TiO2/Fe2O3/CS Nanocomposite: A Therapeutic Solution against Multidrug Resistant E. coli Strains of Livestock Infectious Diseases. Pharmaceutics. 2022; 14(8):1719. https://doi.org/10.3390/pharmaceutics14081719
Chicago/Turabian StyleZafar, Naheed, Bushra Uzair, Farid Menaa, Barkat Ali Khan, Muhammad Bilal Khan Niazi, Fatima S. Alaryani, Kamlah Ali Majrashi, and Shamaila Sajjad. 2022. "RETRACTED: Moringa concanensis-Mediated Synthesis and Characterizations of Ciprofloxacin Encapsulated into Ag/TiO2/Fe2O3/CS Nanocomposite: A Therapeutic Solution against Multidrug Resistant E. coli Strains of Livestock Infectious Diseases" Pharmaceutics 14, no. 8: 1719. https://doi.org/10.3390/pharmaceutics14081719
APA StyleZafar, N., Uzair, B., Menaa, F., Khan, B. A., Niazi, M. B. K., Alaryani, F. S., Majrashi, K. A., & Sajjad, S. (2022). RETRACTED: Moringa concanensis-Mediated Synthesis and Characterizations of Ciprofloxacin Encapsulated into Ag/TiO2/Fe2O3/CS Nanocomposite: A Therapeutic Solution against Multidrug Resistant E. coli Strains of Livestock Infectious Diseases. Pharmaceutics, 14(8), 1719. https://doi.org/10.3390/pharmaceutics14081719

